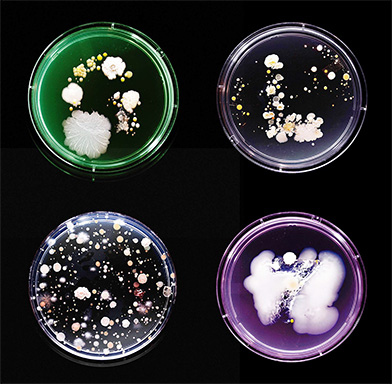

Œuvre artistique intitulée Subvisual Subway, ou la face cachée du métro, réalisée à partir des micro-organismes prélevés dans le métro de New York en 2015 et cultivés dans des boîtes de Petri remplies avec un milieu de culture gélosé. Chaque point correspond à une colonie. Une boîte mesure 9 cm de diamètre. Photo © Craig Ward, 2015
La pandémie actuelle du Coronavirus nous marquera psychologiquement et pour longtemps, au risque d’amplifier une peur collective, surtout dans les grandes métropoles, qui existe déjà et porte un nom. C’est la mysophobie, ou germophobie, c’est-à-dire la phobie des microbes.
Qui n’a pas pensé à la suite de douleurs à l’estomac à la bactérie Helicobacter pylori ? Qui ne s’est jamais inquiété devant les moisissures des maisons comme Aspergillus ? Qui n’a pas fantasmé en pensant au virus Ebola, pourtant cantonné à l’Afrique équatoriale ?La mysophobie naît de l’invisible, et du fait que cet invisible peut se trouver partout. C’est le cas notamment dans les transports en commun. Un projet primé au concours Lépine 2019 est emblématique à cet égard. Quatre étudiants de l’université Paris-Sorbonne ont mis au point un protège-main portatif qui se place sur la paume pour s’agripper aux barres de maintien du métro sans les toucher. Ce dispositif aura probablement du succès dans les années à venir. Mais il faut aussi voir les choses positivement.
Pour contrebalancer la mysophobie ambiante, l’artiste britannique Craig Ward a transformé le monde microbien du métro de New York en œuvre d’art. Il a parcouru les 22 lignes avec des éponges stériles qu’il a appliquées sur diverses surfaces, barres, sièges, etc. Il a ensuite déposé chaque éponge sur un milieu nutritif gélosé qu’il a laissé incuber dans son atelier pendant une semaine. Il en résulte une série d’images intitulée Subvisual Subway, qui révèle un portrait invisible de la ville.
Outre cette œuvre artistique, des projets de recherche ont également vu le jour ces dernières années pour révéler au grand jour les micro-organismes du métro. En 2015, une équipe a publié les résultats d’une campagne de séquençage massif de l’ADN prélevé dans les 468 stations de New York et dans les rames. Le projet a identifié 637 espèces de bactéries dont une plus abondante que les autres, Pseudomonas stutzeri, qui se trouve sur la peau mais aussi dans le sol. Si elle peut être pathogène pour l’homme, elle provoque rarement des maladies. D’autres espèces provenaient du tube digestif et des organes génitaux.
Les chercheurs ont même mis au jour des bactéries… marines. Celles-ci se trouvaient dans une station qui avait été inondée par l’océan lors de l’ouragan Sandy en 2012. S’il n’y a pas de quoi alimenter les peurs, d’autres résultats de cette étude font quand même réfléchir. Parmi les séquences génétiques identifiées dans plusieurs stations se trouvaient celles de Bacillus anthracis, à l’origine de la maladie du charbon, ou anthrax, et de Yersinia pestis, le bacille de la peste bubonique ! Mais, comme pour les cyanobactéries du cuir chevelu ou le microbiote du placenta, des séquences génétiques ne signifient pas que les micro-organismes correspondants soient vivants ou même intacts. Ce qui est également rassurant, c’est qu’aucun cas de maladie du charbon ou de peste n’a été relevé depuis des décennies à New York ou aux alentours.
Un autre séquençage massif d’ADN, publié en 2018, a été réalisé cette fois dans les stations et les rames du métro de Hong Kong. Les chercheurs n’ont pas prélevé les échantillons sur les surfaces comme précédemment, mais sur les paumes des voyageurs. Des volontaires s’étaient lavé les mains selon une procédure standard, puis avaient pris le métro en tenant les rampes, les barres de maintien et d’autres surfaces pendant 30 minutes. Ils devaient voyager aux heures de pointe, soit le matin entre 9 h et 11 h 30, soit l’après-midi entre19 h et 21 h 30. Résultat : 140 espèces de bactéries furent identifiées sur les paumes dont Propionibacterium acnes, qui fait partie du microbiote cutané de la plupart des jeunes et des adultes en bonne santé. Cette bactérie est à l’origine des boutons de la puberté. Les résultats ont également montré que les phages spécifiques à cette espèce étaient aussi abondants.
Si l’on compare les résultats, on s’aperçoit que le nombre d’espèces de bactéries est très différent, 637 dans les stations et les rames du métro de New York et 140 sur les mains des usagers de celui de Hong Kong, ce qui amène deux hypothèses. Les communautés bactériennes du métro ne seraient pas les mêmes selon la ville ou même le pays. Ou alors, les bactéries qui se trouvent dans les stations et les rames ne se retrouveraient pas automatiquement sur les mains. La deuxième hypothèse est plutôt rassurante.
Cet extrait est issu de l'ouvrage :